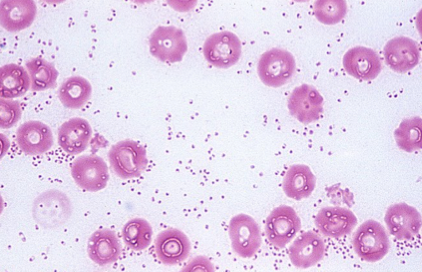

Enterobacteriaceae family members & features

Escherichia important species
-E. coli

Escherichia disease patterns

Escherichia treatment
Salmonella important species
S. enterica subspecies I (or subspecies enterica)

Salmonella disease patterns

Salmonella treatment
*sanitation in reptiles is extremely important
Yersinia important species

Yersinia disease patterns

Yersinia treatment
Shigella disease patterns

Shigella treatment
Pasteurellaceae family members
*all oxidase positive bacteria

Pasteurella (and Bibersteinia and Mannheimia) characteristics & important species
Pasteurella, Bibersteina, Mannheimia disease patterns

Pasteurella treatment
Actinobacillus characteristics & important species

Actinobacillus disease patterns
pneumonia, wound infections, lesions on mammary gland
-“wooden tongue” (granuloma on tongue)- A. lignieresii

Actinobacillus treatment
Haemophilus characteristics

Haemophilus disease patterns

Haemophilus treatment
Histophilus important species
H. somni (depressive effect on CNS)

Histophilus disease patterns
